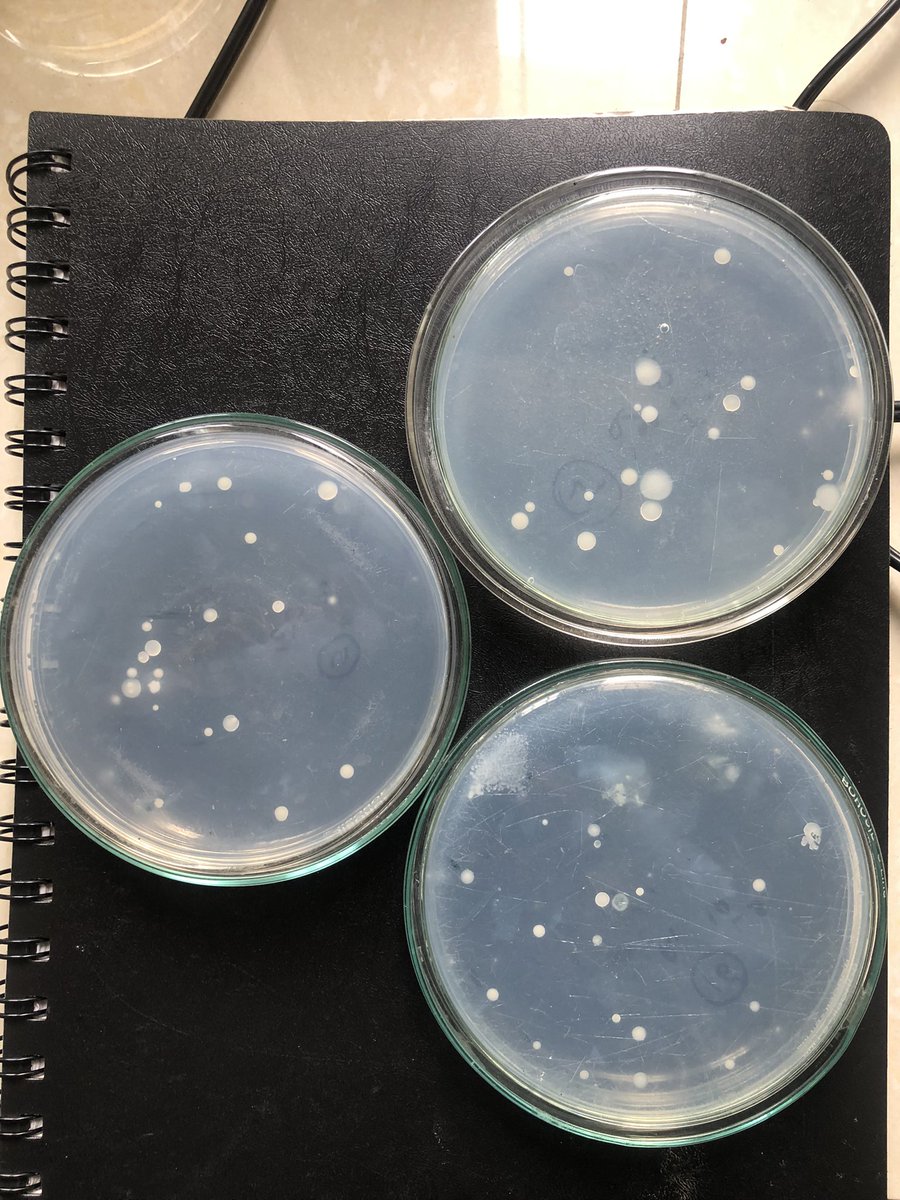
After extensive efforts, I successfully cultured bacteria and actinomycetes from herbicide-treated soils in my research plot! #Microbiology #SoilResearch #BacteriaCulture #Actinomycetes #HerbicideEffects

Nisith Nishank Purohit
@nishanknisith
Graduate research assistant (Weed science), Auburn university
ID: 1644184890685145088
07-04-2023 03:46:51
22 Tweet
70 Takipçi
197 Takip Edilen








Excited to share that I've embarked on a new academic journey by starting my Ph.D. under the guidance of Aniruddha Maity as my Principal Investigator! Looking forward to diving deep into research and contributing to the field. #PhDLife #ResearchJourney #AcademicAdventure



I'm excited to announce that I recently attended ISTRO Conference in Virginia and received the Best Oral Presentation award. A heartfelt thanks and deep appreciation to Aniruddha Maity Bionomics Lab for their continuous support.


A part of Weed Bionomics Lab attended the 2024 ASA meeting. Total 8 presentations, 3 wins. Glad for the hardworking team. Auburn University CSES Auburn University Auburn CSES Club Auburn Agriculture


Great efforts Akashdeep Singh Ankit Yadav Nisith Nishank Purohit , Debra and esra karaca



Fieldwork season of the year is officially here! Time to swap lab coats for sunscreen and get our hands dirty with data. Excited for another summer of science, sweat and auburn weed bionomics team. Aniruddha Maity Auburn University Auburn Agriculture


Latest publication from our PhD student, Nisith Nishank Purohit: "The rapid and intensive expansion of cereal rye as a cover crop for soil conservation and weed suppression may raise concerns about its invasiveness with ecological implications in a few years." acsess.onlinelibrary.wiley.com/doi/10.1002/cs…

Can Cereal Rye Become an Invasive Weed? Thank you Dr. Aniruddha Maity Dr Rakesh Kumar Ghosh and Dr Price for the contributions. dx.doi.org/10.1002/csc2.7… #CoverCrops #InvasiveSpecies SouthernWeedScienceSociety